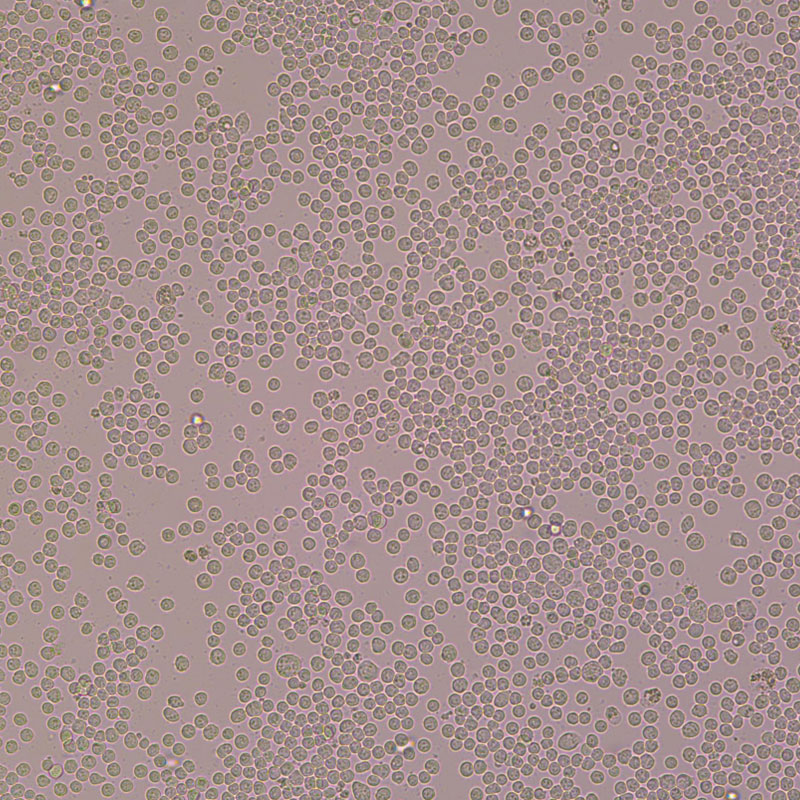
EL4（小鼠淋巴瘤细胞）

EL4(小鼠淋巴瘤细胞)
EL4
¥1480
1瓶
起订
湖北 更新日期:2023-12-18
产品详情:
- 中文名称:
- EL4(小鼠淋巴瘤细胞)
- 英文名称:
- EL4
- 产品类别:
- 细胞系
公司简介
武汉尚恩生物技术有限公司专注于细胞产品的研究、生产、销售和服务。公司经过国家相关部门认证的“高新技术企业”,先后通过了ISO认证和部分产品CE认证。
我们拥有一套完整的研发、生产、质检、销售和运营团队;已完成从细胞辅助器材、细胞产品到细胞相关专业化服务的全细胞产业链发展布局;具备制造细胞产品、相关试剂及代做细胞实验的系统化专业能力。
产品种类包含细胞系、原代细胞、胎牛血清、辅助试剂、基础培养基、完全培养基、无血清培养基、无血清非程序冻存液等,细胞培养配套试剂一站式采购;细胞库储存细胞品种有500余种,可满足80%生物实验室的需求。
我们拥有丰富的市场管理经验和渠道管理能力,为产品经销商及终端客户提供完善的专业化服务。 把客户提供优质的产品作为企业的尊严和责任,通过不断的技术创新,为客户提供优质的产品和服务。
| 成立日期 | (12年) |
| 注册资本 | 100w |
| 员工人数 | 10-50人 |
| 年营业额 | ¥ 500万-1000万 |
| 经营模式 | 贸易,工厂,试剂,定制,服务 |
| 主营行业 | 细胞培养 |
EL4(小鼠淋巴瘤细胞)相关厂家报价 更多
-

- EL4细胞
- 上海雅吉生物科技有限公司 VIP
- 2026-04-26
- ¥1800
-

- EL4EL4小鼠淋巴瘤复苏细胞(附STR鉴定报告)
- 上海冠导生物工程有限公司 VIP
- 2026-04-26
- ¥1125
-

- EL4 EL4小鼠淋巴瘤细胞系
- 上海宾穗生物科技有限公司 VIP
- 2026-04-26
- ¥1232
-

- EL4(小鼠淋巴瘤细胞)
- 澳培赛生物科技(上海)有限公司 VIP
- 2026-04-24
- ¥1800
-

- EL4(小鼠淋巴瘤细胞)
- 上海沪震实业有限公司 VIP
- 2026-04-24
- ¥1500
-

- EL-4小鼠淋巴瘤细胞
- 上海博湖生物科技有限公司 VIP
- 2026-04-24
- ¥1800
-
- EL4
- 武汉百意欣生物技术有限公司
- 2026-04-21
- 询价
-
- EL4
- 上海奥陆生物科技有限公司
- 2026-04-21
- ¥1200
-
- EL4
- 北京智杰方远科技有限公司
- 2026-04-21
- 询价
-
- EL4
- 上海匹拓生物科技有限公司
- 2026-04-21
- 询价